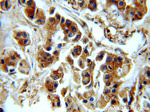
EEF2 Antibody in Immunohistochemistry (Paraffin) (IHC (P))

Search
Proteintech
EEF2 Polyclonal Antibody
{{$productOrderCtrl.translations['antibody.pdp.commerceCard.promotion.promotions']}}
{{$productOrderCtrl.translations['antibody.pdp.commerceCard.promotion.viewpromo']}}
{{$productOrderCtrl.translations['antibody.pdp.commerceCard.promotion.promocode']}}: {{promo.promoCode}} {{promo.promoTitle}} {{promo.promoDescription}}. {{$productOrderCtrl.translations['antibody.pdp.commerceCard.promotion.learnmore']}}
产品信息
20107-1-AP
种属反应
已发表种属
宿主/亚型
分类
类型
抗原
偶联物
形式
浓度
规格
纯化类型
保存液
内含物
保存条件
运输条件
产品详细信息
Immunogen sequence: VEAKNPADL PKLVEGLKRL AKSDPMVQCI IEESGEHIIA GAGELHLEIC LKDLEEDHAC IPIKKSDPVV SYRETVSEES NVLCLSKSPN KHNRLYMKAR PFPDGLAEDI DKGEVSARQE LKQRARYLAE KYEWDVAEAR KIWCFGPDGT GPNILTDITK GVQYLNEIKD SVVAGFQWAT KEGALCEENM RGVRFDVHDV TLHADAIHRG GGQIIPTARR CLYASVLTAQ PRLMEPIYLV EIQCPEQVVG GIYGVLNRKR GHVFEESQVA GTPMFVVKAY LPVNESFGFT ADLRSNTGGQ AFPQCVFDHW QILPGDPFDN SSRPSQVVAE TRKRKGLKEG IPALDNFLDK L (509-858 aa encoded by BC126259)
靶标信息
Catalyzes the GTP-dependent ribosomal translocation step during translation elongation. During this step, the ribosome changes from the pre-translocational (PRE) to the post-translocational (POST) state as the newly formed A-site-bound peptidyl-tRNA and P-site-bound deacylated tRNA move to the P and E sites, respectively. Catalyzes the coordinated movement of the two tRNA molecules, the mRNA and conformational changes in the ribosome.
仅用于科研。不用于诊断过程。未经明确授权不得转售。
生物信息学
蛋白别名: EF-2; Elongation factor 2; epididymis secretory sperm binding protein; polypeptidyl-tRNA translocase; unnamed protein product
基因别名: EEF-2; EEF2; EF-2; EF2; SCA26
UniProt ID: (Human) P13639, (Mouse) P58252
Entrez Gene ID: (Human) 1938, (Mouse) 13629